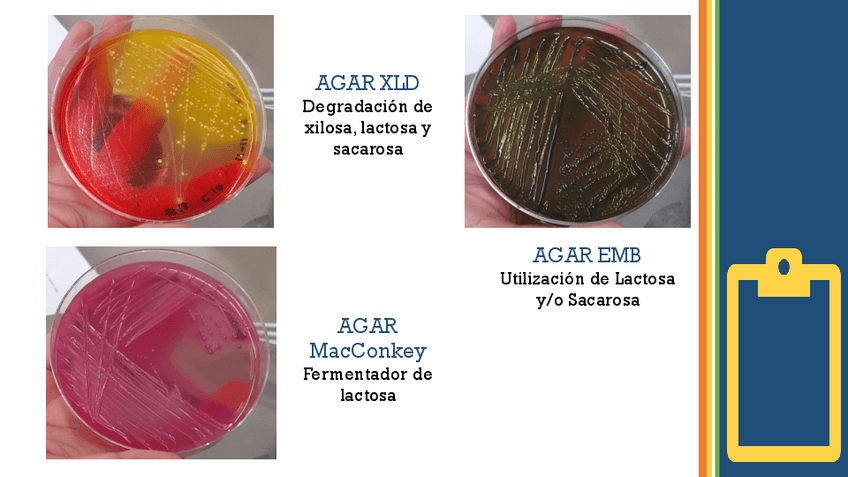

Morfología
Todo
Apuntes
chevron_left
chevron_right
He publicado nuevos apuntes de 2º Morfología: Metodos-de-tincion-para-parasitos-intestinales-y-extraintestinales.pdf
He publicado nuevos apuntes de 2º Morfología: Patogenos-vias-respiratorias..pdf
He publicado nuevos apuntes de 2º Morfología: Pruebas-bioquimicas-e.coli.pdf
He publicado nuevos apuntes de 2º Morfología: Desarrollo-de-aparatos-.pdf
He publicado nuevos apuntes de 2º Morfología: Desarrollo-embrionario.pdf
He publicado nuevos apuntes de 2º Morfología: Investigacion-Sindromes-Citologia-Exfoliativa.pdf
apuntes
-
VIRUS DEL PAPILOMA HUMANO
He publicado nuevos apuntes de 2º Morfología: VIRUS DEL PAPILOMA HUMANO

¡Estás al día!
Has visto todos los archivos